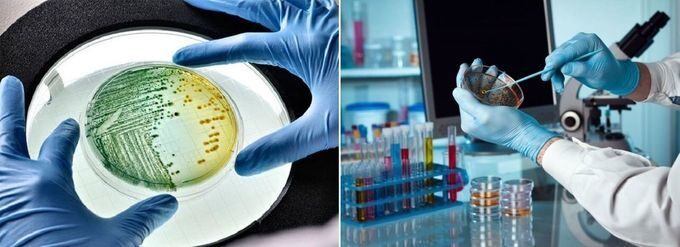
Лабалаторный анализ на дисбактериоз

Ставить себе диагноз Дисбактериоз и отправляться в аптеку за упаковкой пробиотиков как минимум легкомысленно. Если небольшой дискомфорт в животе – это временное явление, то пробиотики станут бесполезной тратой денег. Если же имеющиеся симптомы являются проявлением серьезного заболевания, то прием бесполезных препаратов приведет к потере времени и позднему обращению к врачу.
Симптомов, прямо указывающих на нарушение соотношения «полезных» и «вредных» микроорганизмов в кишечнике, нет. Поставить диагноз можно только на основании лабораторных тестов.
Как проводится анализ?
Для исследования в лабораторию необходимо будет сдать образец кала. Проще всего собирать кал в специально предназначенный для этого контейнер с плотно закручивающейся крышкой и ложечкой. При помощи ложечки нужно с листа бумаги или обработанного кипятком подкладного судка собрать 10-15 мл кала. Выбирать необходимо фрагменты без видимых непереваренных кусочков пищи.
Собирая кал на анализ, необходимо избегать попадания на него мочи. Женщинам лучше дождаться окончания менструаций или же использовать вагинальный тампон.
В доставленном в лабораторию образце определяется количество полезных, условно-патогенных и патогенных микроорганизмов. Всего может быть выявлено несколько десятков видов кишечных бактерий.
Интерпретация результатов
Для расшифровки полученных данных мало посмотреть нормальные значения анализа кала на дисбактериоз. Также необходимо знать соотношение «полезных» и «вредных» бактерий и ряд других важных параметров. Обычно интерпретировать результаты берутся лишь врачи-гастроэнтерологи, у которых есть необходимый опыт и знания. К такому врачу и стоит обратиться за разъяснениями, а также возможным лечением.
Сколько стоит обследование?
Цена услуги определяется целым рядом параметров:
- количеством определяемых показателей;
- методом, используемым для проведения теста;
- сроки проведения исследования (срочные тесты стоят дороже).
Приобретение емкость для сбора анализов тоже может потребовать трат. В ряде клиник, например, в лаборатории ЦМД в Москве получить контейнер для сбора кала можно в регистратуре учреждения абсолютно бесплатно.
Если говорить о самодиагностике и самолечении, то стоимость лабораторного теста обойдется дешевле упаковки бесполезного аптечного препарата. А в случае выявления проблемы модно будет получить адекватную медицинскую помощь.